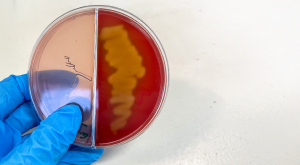

Module 1: Vaccine-Preventable Pneumonia Series: Not so sweet! Capsular polysaccharide type 3 and pneumococcal disease
Vaccine-Preventable Pneumonia Series: Which Streptococci are causing pneumonia deaths in South Africa? Presenting the evidence to guide the clinician's selection of preventative vaccines for children and older adults
Learning objectives
You will learn:
- Insights regarding the variable pathogenesis of different Streptococcus pneumoniae serotypes (STs) and the important role of capsule polysaccharide in virulence
- An understanding of why pneumococcal vaccine strategies are influenced by ongoing and sustained monitoring of STs associated with invasive pneumococcal disease (IPD) and mortality
- An awareness of IPD STs associated with pneumococcal vaccine breakthrough and unique features of ST3 that enable vaccine escape
- The impact of different pneumococcal conjugate vaccines (PCVs) as routine childhood vaccinations in South Africa
- Clinical evidence demonstrating the safety and efficacy of PCV15, especially in relation to ST3.
To access this module, please register or login:
